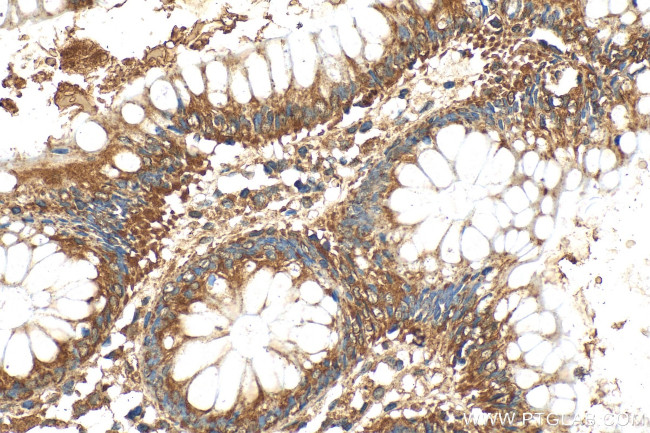
SOCS6 Antibody in Immunohistochemistry (Paraffin) (IHC (P))

Search
Proteintech
SOCS6 Polyclonal Antibody
{{$productOrderCtrl.translations['antibody.pdp.commerceCard.promotion.promotions']}}
{{$productOrderCtrl.translations['antibody.pdp.commerceCard.promotion.viewpromo']}}
{{$productOrderCtrl.translations['antibody.pdp.commerceCard.promotion.promocode']}}: {{promo.promoCode}} {{promo.promoTitle}} {{promo.promoDescription}}. {{$productOrderCtrl.translations['antibody.pdp.commerceCard.promotion.learnmore']}}
产品信息
27343-1-AP
种属反应
宿主/亚型
分类
类型
抗原
偶联物
形式
浓度
规格
纯化类型
保存液
内含物
保存条件
运输条件
产品详细信息
Immunogen sequence: YSPAPWPLRP TNSEETCIKM EVRVKALVHS SSPSPALNGV RKDFHDLQSE TTCQEQANSL KSSASHNGDL HLHLDEHVPV VIGLMPQDYI QYTVPLDEGM YPLEGSRSYC LDSSSPMEVS AVPPQVGGRA FPEDESQVDQ DLVVAPEIFV DQSVNGLLIG TTGVMLQSPR AGHDDVPPLS PLLPPMQNNQ IQRNFSGLTG TEAHVAESMR CHLNFDPNSA PGVARVYDSV QSSGPMVVTS LTEELKKLAK QGWY
靶标信息
The eight members of the recently identified Suppressor of Cytokines Signaling (SOCS) family are SOCS1, SOCS2, SOCS3, SOCS4, SOCS5, SOCS6, SOCS7, and CIS. Structurally the SOCS proteins are composed of an N- terminal region of variable length and amino acid composition, a central SH2 domain, and a C-terminal motif called the SOCS box. The SOCS proteins appear to form part of a classical negative feedback loop that regulates cytokine signal transduction. Transcription of each of the SOCS genes occurs rapidly in vitro and in vivo in response to cytokines, and once produced, the various members of the SOCS family appear to inhibit signaling in different ways. SOCS1 and SOCS6 interact with the insulin receptor (IR) when expressed in human hepatoma cells (HepG2) or in rat hepatoma cells overexpressing human IR. SOCS1 and SOCS6 inhibit insulin-dependent activation of ERK1/2 and protein kinase B in vivo and IR- directed phosphorylation of IRS1 in vitro. These results suggest that SOCS proteins may be inhibitors of IR signalling and could mediate cytokine-induced insulin resistance and contribute to the pathogenesis of type II diabetes.
仅用于科研。不用于诊断过程。未经明确授权不得转售。
篇参考文献 (0)
生物信息学
蛋白别名: CIS-4; cytokine inducible SH2-containing protein 4; cytokine inducible SH2-containing protein CIS4; Cytokine-inducible SH2 protein 4; SH2 domain containing SOCS box protein SOCS6; SOCS-4; SOCS-6; STAT induced STAT inhibitor-4; Suppressor of cytokine signaling 4; Suppressor of cytokine signaling 6
基因别名: 1500012M23Rik; 5830401B18Rik; AI447482; CIS-4; CIS4; Cish4; HSPC060; SOCS-4; SOCS-6; SOCS4; SOCS6; SSI4; STAI4; STATI4
UniProt ID: (Human) O14544, (Mouse) Q9JLY0
Entrez Gene ID: (Human) 9306, (Mouse) 54607